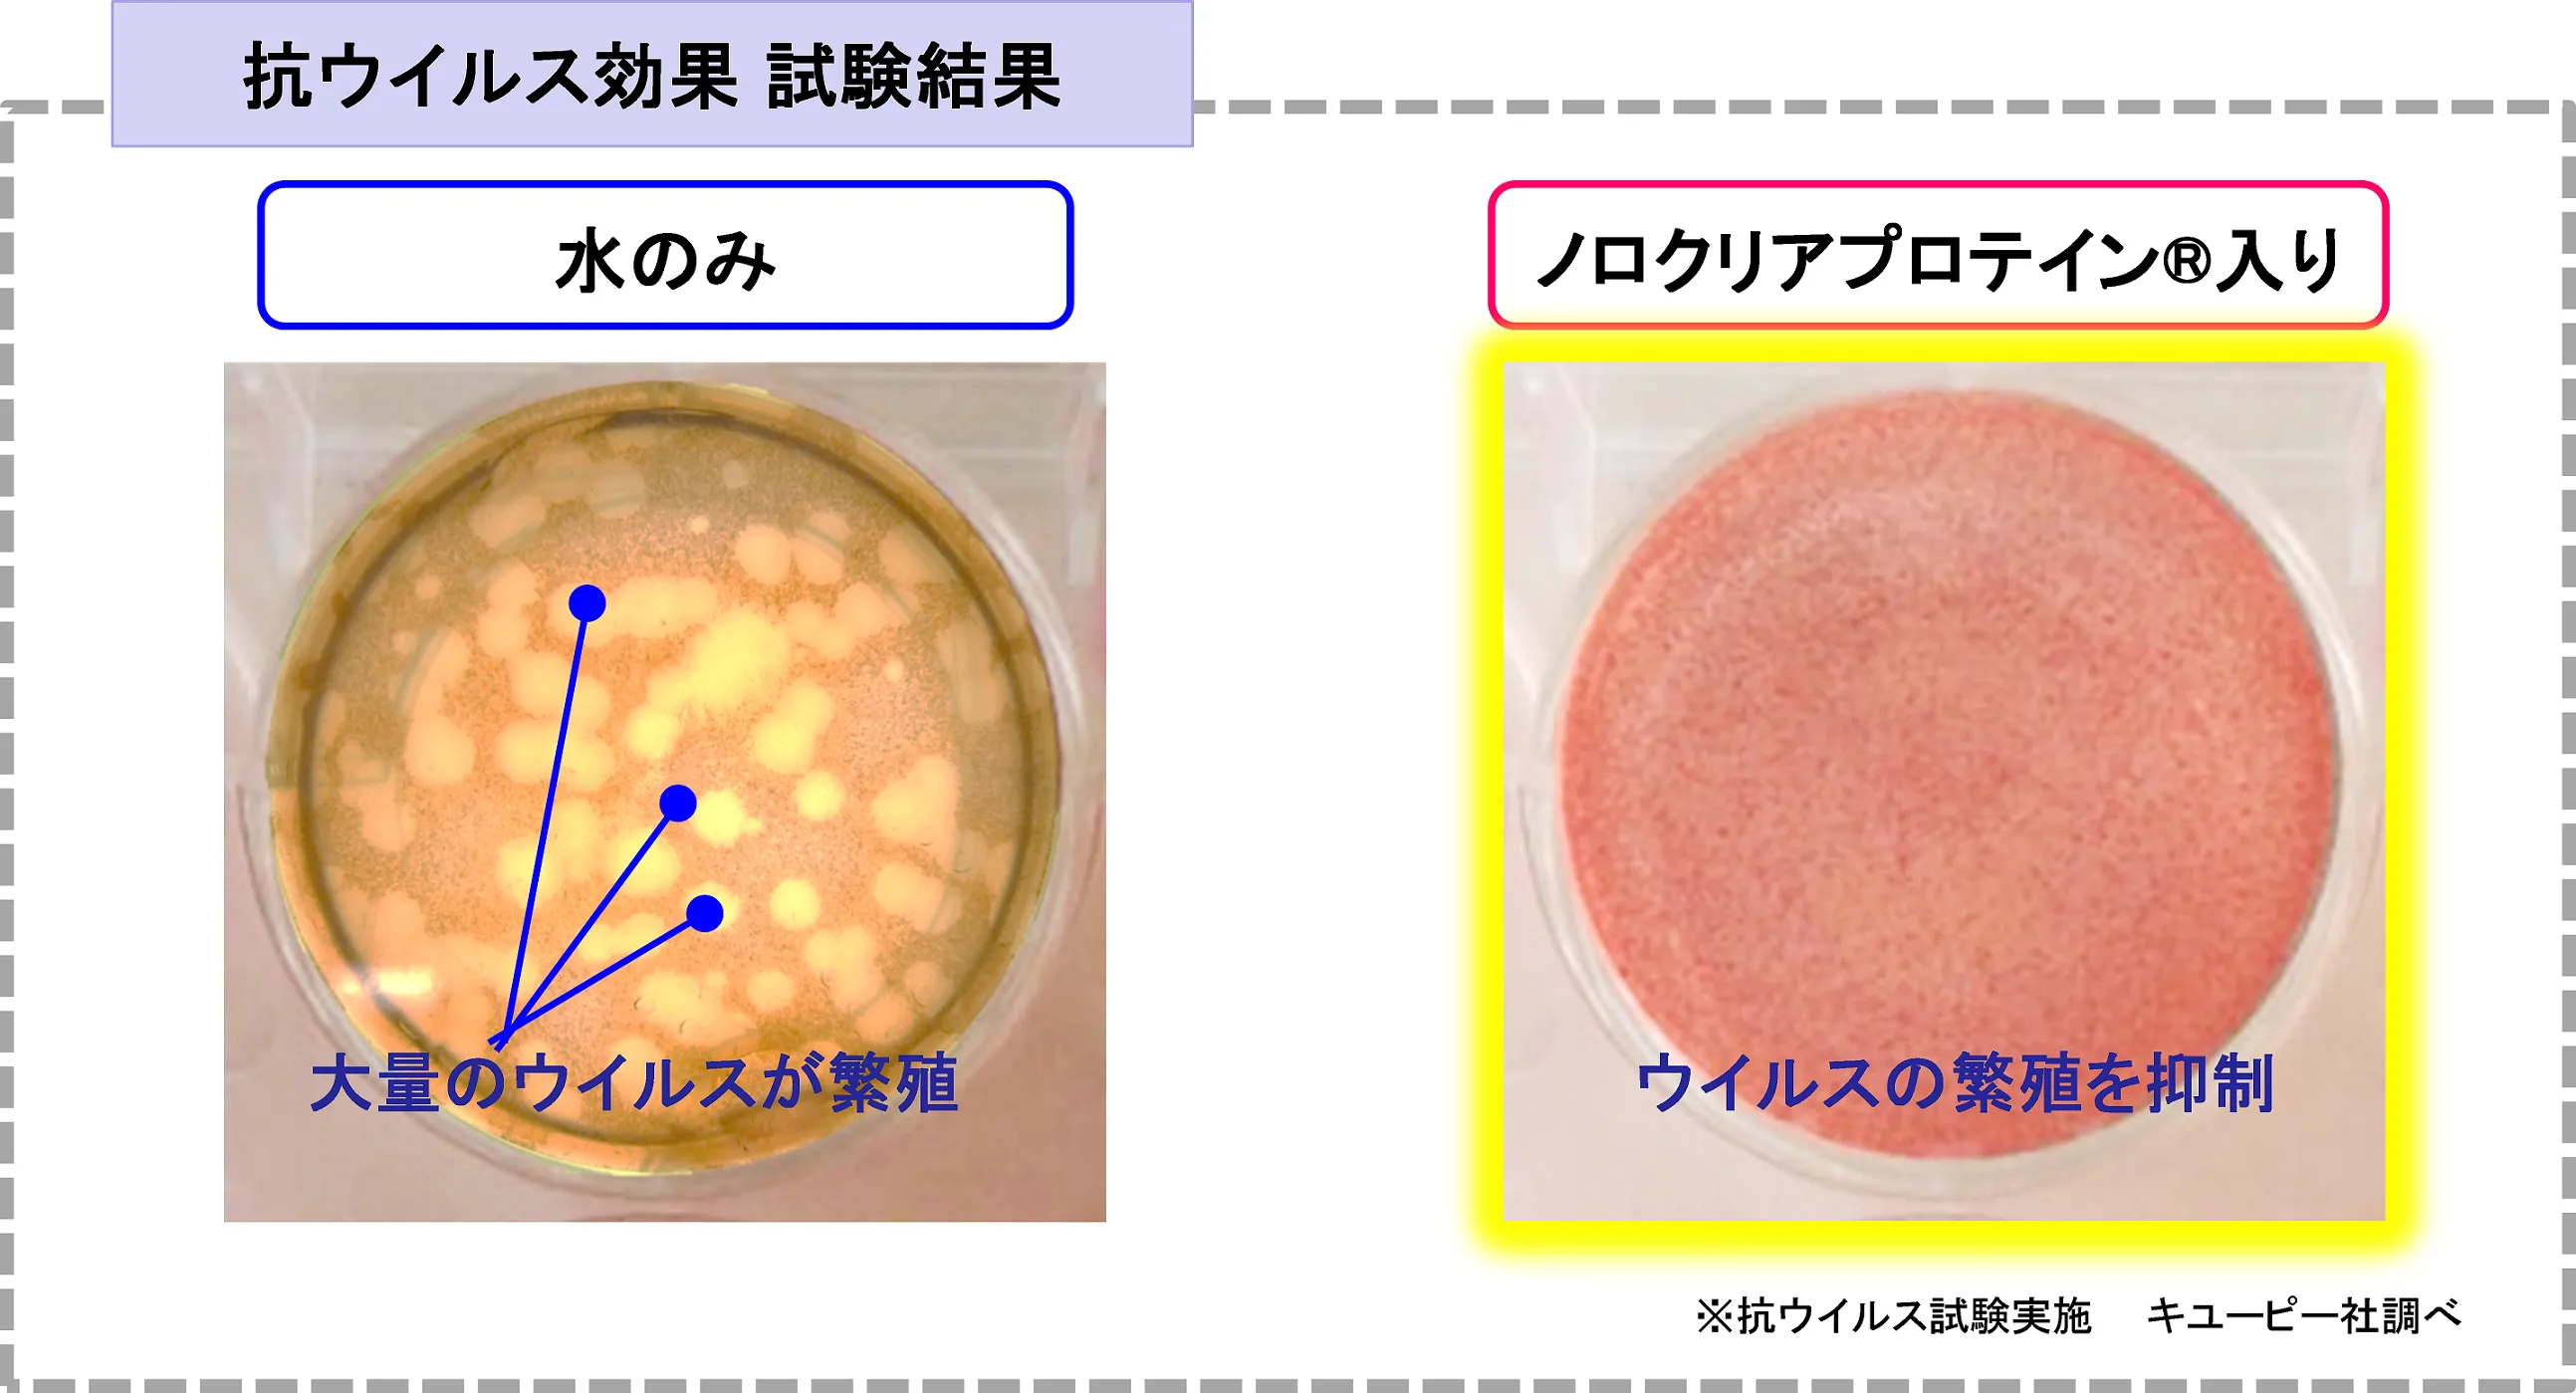

キユーピー株式会社が開発協力 自然由来の抗ウイルス成分「ノロクリアプロテイン(R)」配合 『シルコット ノロクリア(R)ウェット除菌※1』 2019年10月8日より全国で新発売
ユニ・チャーム株式会社(本社:東京都港区、代表取締役 社長執行役員:高原 豪久)は、キユーピー株式会社が開発した100%自然由来の抗ウイルス成分「ノロクリアプロテイン(R)」を配合した『シルコット ノロクリア(R)ウェット除菌※1』を、2019年10月8日より全国で新発売します。
※1 全ての菌を除菌するわけではありません

1枚目
デザインは一部変更になる場合があります。
■発売の背景
ウェットティッシュ市場は、使用率の高まりにより年々拡大しています。一方で、消費者ニーズは「身の回りをキレイにする」から「しっかり除菌できること」へ直近数年間で変化しています。
また、安心・安全ニーズの高まりから、次亜塩素酸に代表される「強力なモノ」から、「成分が身体に安全なモノ、自然由来のモノ」に変わってきています。
そこでこの度、キユーピー株式会社が開発した、身体に安心・安全の100%自然由来の抗ウイルス成分「ノロクリアプロテイン(R)」を配合した『シルコット ノロクリア(R)ウェット除菌※1』を、2019年10月8日より全国で発売します。

2枚目
■商品の特長
<特長(1)容器>
「片手でポン!」のシルコットボックス容器!

3枚目
<特長(2)薬液>
アルコールタイプ!
自然由来の抗ウイルス成分「ノロクリアプロテイン(R)」を配合

4枚目
【抗ウイルス成分(ノロクリアプロテイン(R))の効果】
5枚目
抗ウイルス成分「ノロクリアプロテイン(R)」により、ウイルスの増殖を抑制※2
※2 全ての細菌・ウイルスを抑制するものではありません。
データ:キユーピー社調べ
<特長(3)不織布>
対人用で初※3の厚手メッシュシート採用!
見えない菌までひと拭きでしっかり除菌
※3 シルコットウェットティッシュ内

6枚目
■『シルコット ノロクリア(R)ウェット』の入数・価格
商品名:シルコット ノロクリア(R)ウェット除菌 本体
入数 :40枚
商品名:シルコット ノロクリア(R)ウェット除菌 詰替
入数 :40枚×3
商品名:シルコット ノロクリア(R)ウェット除菌 外出用
入数 :24枚
価格:オープンプライス
■発売時期
2019年10月8日より全国で新発売します。(日付は当社からの出荷日です)
■会社概要
社名 :ユニ・チャーム株式会社
設立 :1961年2月10日
本店 :愛媛県四国中央市金生町下分182番地
本社 :東京都港区三田3-5-27 住友不動産三田ツインビル西館
社員数 :グループ合計15,757名(2017年12月)
事業内容:ベビーケア関連製品、フェミニンケア関連製品、
ヘルスケア関連製品、化粧パフ、ハウスホールド製品、
ペットケア関連製品、産業資材、食品包材等の販売
≪消費者の方のお問い合わせ先≫
ユニ・チャーム株式会社 お客様相談センター
TEL:0120-573-001
ユニ・チャーム株式会社 ホームページアドレス








![K-POP第5世代の自主制作グループONE PACT
8か月ぶりとなる日本公演 [ONE PACT : BLUE HOUR]
7月19日(日)開催決定!](/releases/604499/LL_img_604499_1.jpeg)














